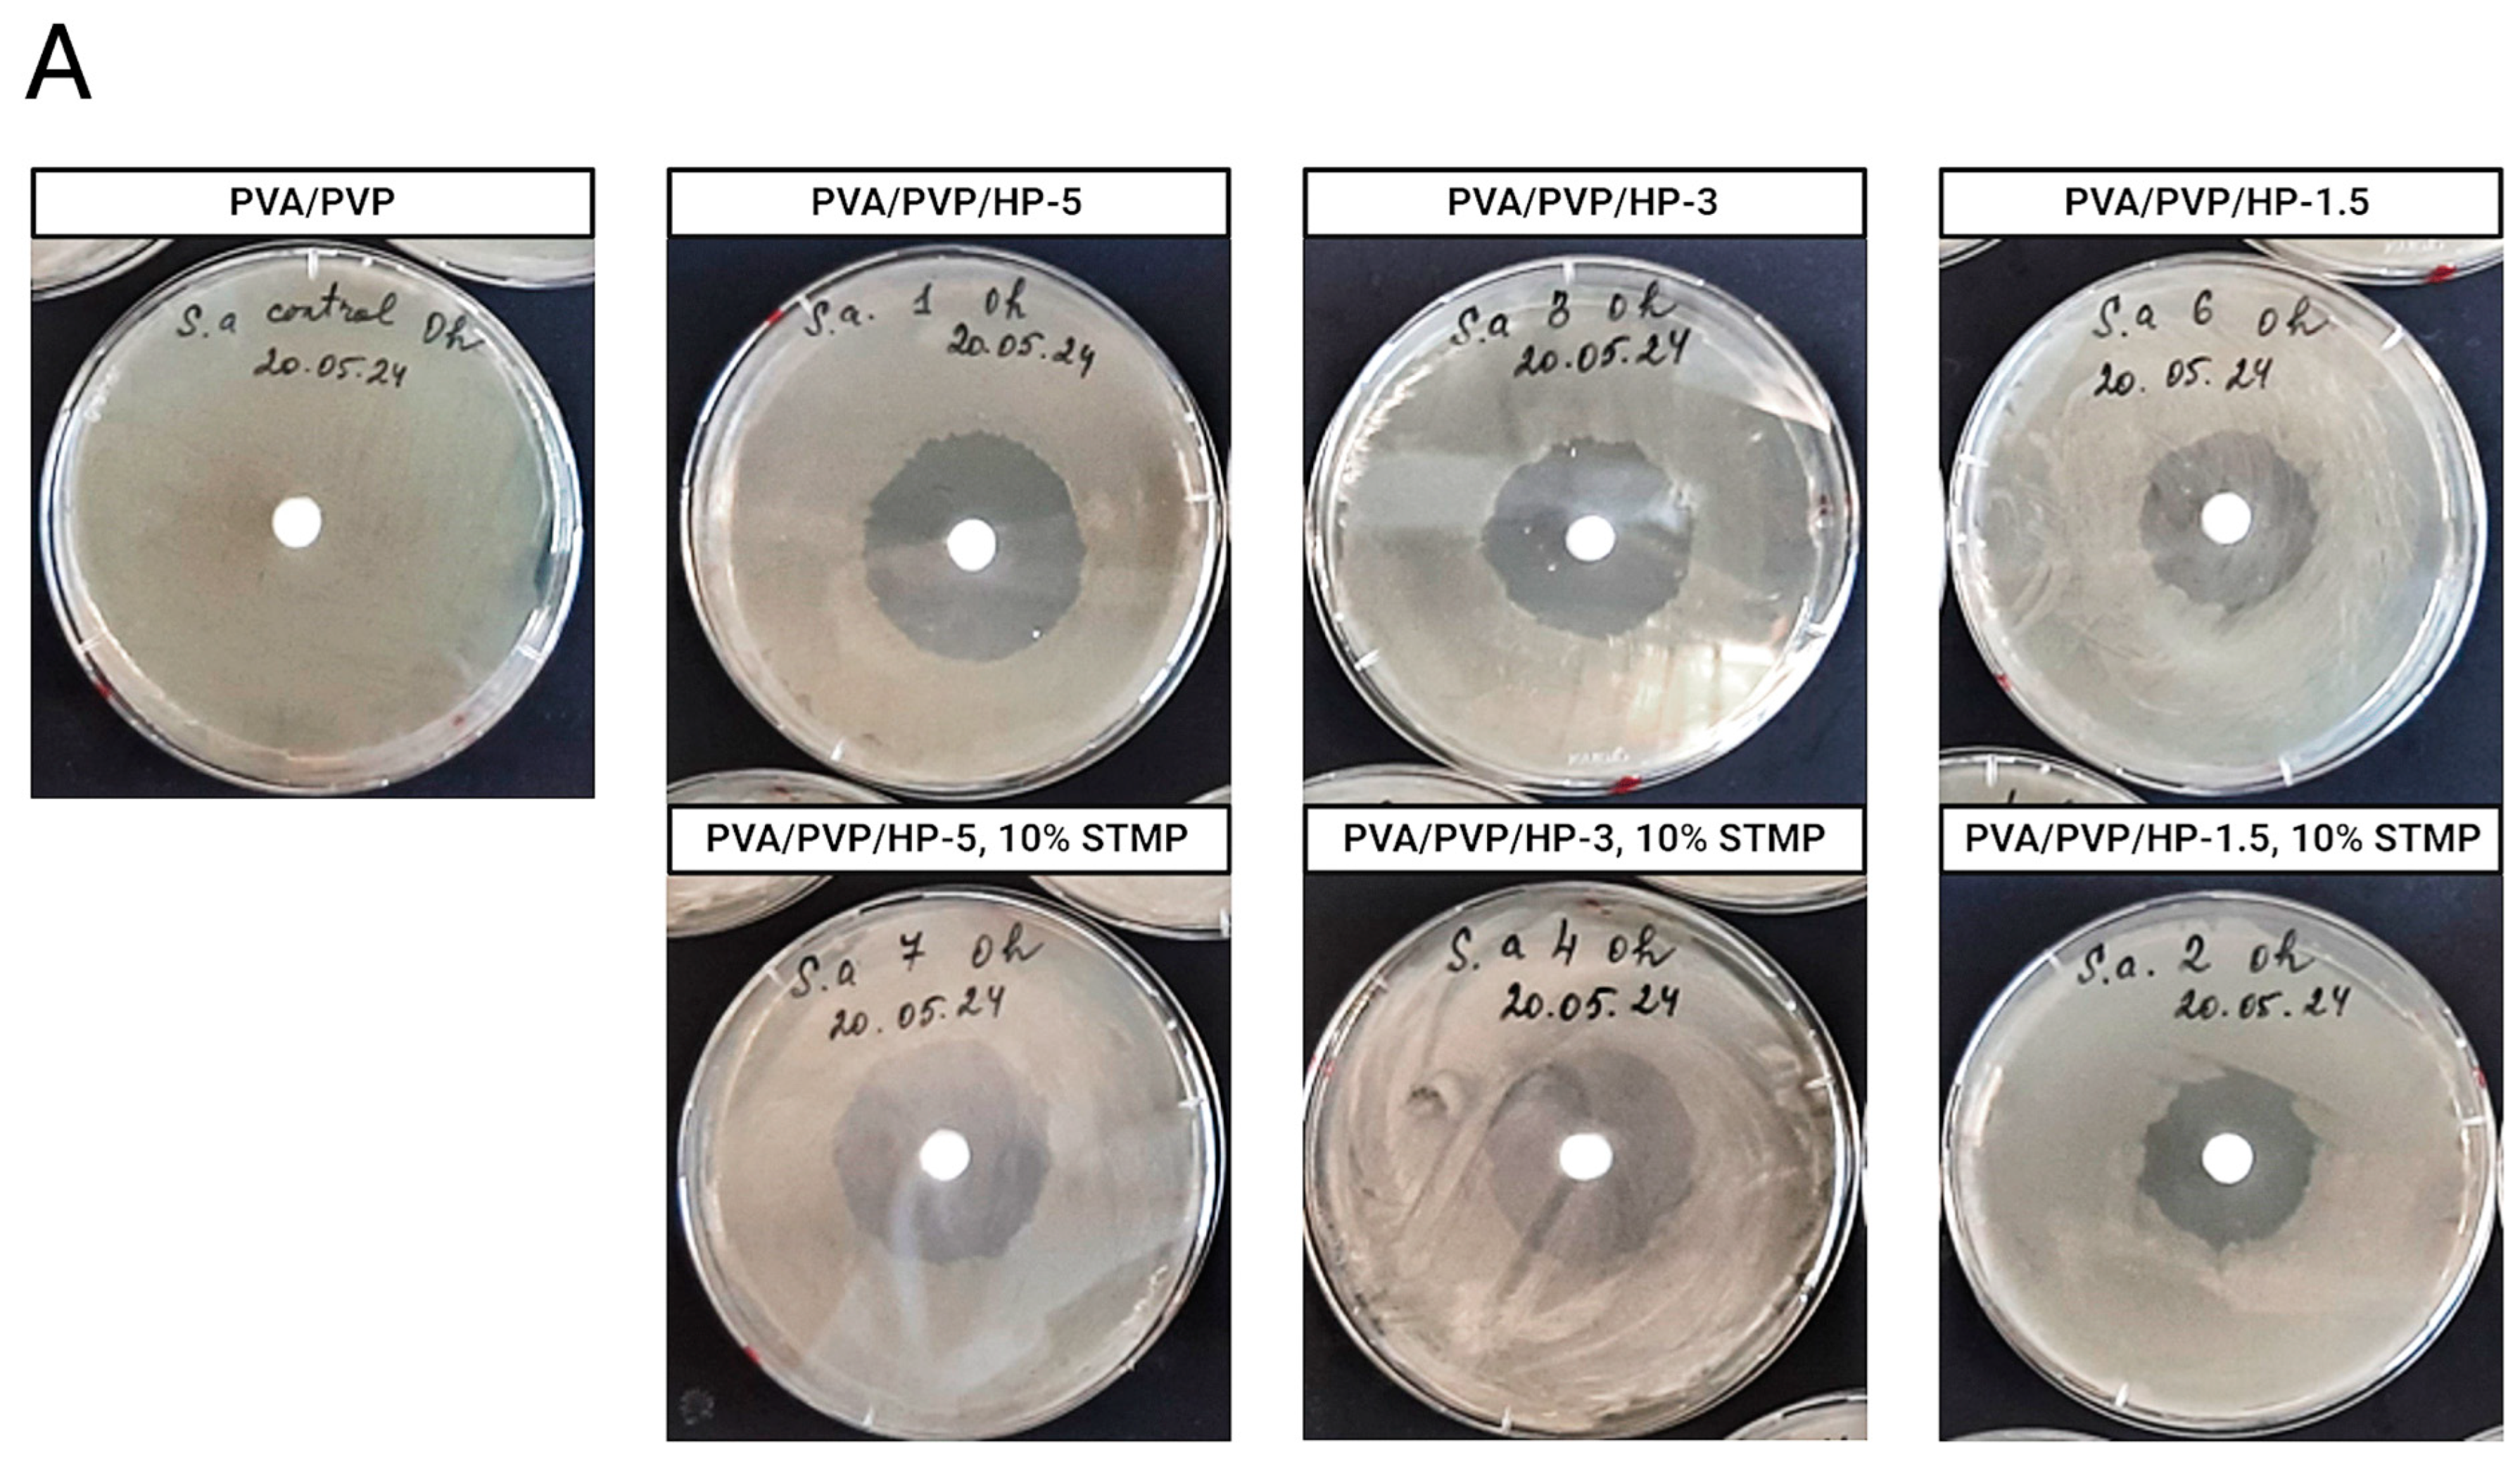
Gels 11 00031 g003a

Encapsulation of Hydrogen Peroxide in PVA/PVP Hydrogels for Medical Applications
Abstract
1. Introduction
2. Results and Discussion
2.1. Preparation of the Different PVA/PVP/HP Hydrogels
2.2. In Vitro: Agar Disk Diffusion Test to Assess the Antibacterial Activity of the Hydrogels
2.3. Controlled Release Kinetics of HP from the Hydrogels
2.4. Characterization
2.4.1. Water-Swelling Capacity of the PVA/PVP Hydrogels
2.4.2. FTIR/ATR Spectra of the PVA/PVP Hydrogels
2.4.3. E-SEM Surface Morphology of Hydrogels
3. Conclusions
4. Materials and Methods
4.1. Materials
4.2. Methods
4.2.1. Preparation of PVA/PVP Hydrogels
4.2.2. Preparation of Chemically Crosslinked Hydrogel with STMP
4.2.3. In Vitro: Disk Diffusion Test to Assess the Anti-Septic Behavior of HP Controlled Release from PVA/PVP Hydrogels
4.2.4. Controlled Release Rate of HP from the PVA/PVP/HP Hydrogels on Ex Vivo Skin Model
4.2.5. Determination of HP Content of the PVA/PVP/HP Hydrogels
4.3. Characterization of the Hydrogels
4.3.1. Swelling Test
4.3.2. Fourier Transform Infrared (FTIR) Spectroscopy
4.3.3. Scanning Electron Microscope (E-SEM)
Author Contributions
Funding
Institutional Review Board Statement
Informed Consent Statement
Data Availability Statement
Acknowledgments
Conflicts of Interest
References
- Wang, W.; Narain, R.; Zeng, H. Chapter 10—Hydrogels. In Polymer Science and Nanotechnology; Narain, R., Ed.; Elsevier: Amsterdam, The Netherlands, 2020; pp. 203–244. [Google Scholar] [CrossRef]
- Gul, K.; Gan, R.-Y.; Sun, C.-X.; Jiao, G.; Wu, D.-T.; Li, H.-B.; Kenaan, A.; Corke, H.; Fang, Y.-P. Recent Advances in the Structure, Synthesis, and Applications of Natural Polymeric Hydrogels. Crit. Rev. Food Sci. Nutr. 2022, 62, 3817–3832. [Google Scholar] [CrossRef]
- Batista, R.A.; Espitia, P.J.P.; Quintans, J.d.S.S.; Freitas, M.M.; Cerqueira, M.Â.; Teixeira, J.A.; Cardoso, J.C. Hydrogel as an Alternative Structure for Food Packaging Systems. Carbohydr. Polym. 2019, 205, 106–116. [Google Scholar] [CrossRef]
- Gökmen, F.Ö. PVP/PVA Blended Hydrogels as a Biofilm for Use in Food Packaging Applications. Food Health 2022, 8, 172–180. [Google Scholar] [CrossRef]
- Ozcelik, B. 7—Degradable Hydrogel Systems for Biomedical Applications. In Biosynthetic Polymers for Medical Applications; Poole-Warren, L., Martens, P., Green, R., Eds.; Woodhead Publishing Series in Biomaterials; Woodhead Publishing: Sawston, UK, 2016; pp. 173–188. [Google Scholar] [CrossRef]
- Cao, H.; Duan, L.; Zhang, Y.; Cao, J.; Zhang, K. Current Hydrogel Advances in Physicochemical and Biological Response-Driven Biomedical Application Diversity. Signal Transduct. Target. Ther. 2021, 6, 426. [Google Scholar] [CrossRef]
- Malka, E.; Margel, S. Engineering of PVA/PVP Hydrogels for Agricultural Applications. Gels 2023, 9, 895. [Google Scholar] [CrossRef] [PubMed]
- Teodorescu, M.; Bercea, M.; Morariu, S. Biomaterials of PVA and PVP in Medical and Pharmaceutical Applications: Perspectives and Challenges. Biotechnol. Adv. 2019, 37, 109–131. [Google Scholar] [CrossRef]
- Husain, M.S.B.; Gupta, A.; Alashwal, B.Y.; Sharma, S. Synthesis of PVA/PVP Based Hydrogel for Biomedical Applications: A Review. Energy Sources Part A Recovery Util. Environ. Eff. 2018, 40, 2388–2393. [Google Scholar] [CrossRef]
- Qiu, H.; Pu, F.; Liu, Z.; Liu, X.; Dong, K.; Liu, C.; Ren, J.; Qu, X. Hydrogel-Based Artificial Enzyme for Combating Bacteria and Accelerating Wound Healing. Nano Res. 2020, 13, 496–502. [Google Scholar] [CrossRef]
- Huang, M.; Hou, Y.; Li, Y.; Wang, D.; Zhang, L. High Performances of Dual Network PVA Hydrogel Modified by PVP Using Borax as the Structure-Forming Accelerator. Des. Monomers Polym. 2017, 20, 505–513. [Google Scholar] [CrossRef]
- Huang, J.; Yang, S.; Zhang, S. Performance and Diversity of Polyvinyl Alcohol-Degrading Bacteria under Aerobic and Anaerobic Conditions. Biotechnol. Lett. 2016, 38, 1875–1880. [Google Scholar] [CrossRef] [PubMed]
- Aslam, M.; Kalyar, M.A.; Raza, Z.A. Polyvinyl Alcohol: A Review of Research Status and Use of Polyvinyl Alcohol Based Nanocomposites. Polym. Eng. Sci. 2018, 58, 2119–2132. [Google Scholar] [CrossRef]
- Huang, Y.; Zhou, T.; He, S.; Xiao, H.; Dai, H.; Yuan, B.; Chen, X.; Yang, X. Flame-Retardant Polyvinyl Alcohol/Cellulose Nanofibers Hybrid Carbon Aerogel by Freeze Drying with Ultra-Low Phosphorus. Appl. Surf. Sci. 2019, 497, 143775. [Google Scholar] [CrossRef]
- Mansur, H.S.; Sadahira, C.M.; Souza, A.N.; Mansur, A.A.P. FTIR Spectroscopy Characterization of Poly (Vinyl Alcohol) Hydrogel with Different Hydrolysis Degree and Chemically Crosslinked with Glutaraldehyde. Mater. Sci. Eng. C 2008, 28, 539–548. [Google Scholar] [CrossRef]
- Terzioğlu, P.; Güney, F.; Parın, F.N.; Şen, İ.; Tuna, S. Biowaste Orange Peel Incorporated Chitosan/Polyvinyl Alcohol Composite Films for Food Packaging Applications. Food Packag. Shelf Life 2021, 30, 100742. [Google Scholar] [CrossRef]
- Chaouat, M.; Le Visage, C.; Baille, W.E.; Escoubet, B.; Chaubet, F.; Mateescu, M.A.; Letourneur, D. A Novel Cross-Linked Poly(Vinyl Alcohol) (PVA) for Vascular Grafts. Adv. Funct. Mater. 2008, 18, 2855–2861. [Google Scholar] [CrossRef]
- Jayakumar, A.; Radoor, S.; Nair, I.C.; Siengchin, S.; Parameswaranpillai, J.; Radhakrishnan, E.K. Polyvinyl Alcohol—Nanocomposite Films Incorporated with Clay Nanoparticles and Lipopeptides as Active Food Wraps against Food Spoilage Microbes. Food Packag. Shelf Life 2021, 30, 100727. [Google Scholar] [CrossRef]
- Bellelli, M.; Licciardello, F.; Pulvirenti, A.; Fava, P. Properties of Poly(Vinyl Alcohol) Films as Determined by Thermal Curing and Addition of Polyfunctional Organic Acids. Food Packag. Shelf Life 2018, 18, 95–100. [Google Scholar] [CrossRef]
- Kanatt, S.R.; Rao, M.S.; Chawla, S.P.; Sharma, A. Active Chitosan–Polyvinyl Alcohol Films with Natural Extracts. Food Hydrocoll. 2012, 29, 290–297. [Google Scholar] [CrossRef]
- Gregorova, A.; Saha, N.; Kitano, T.; Saha, P. Hydrothermal Effect and Mechanical Stress Properties of Carboxymethylcellulose Based Hydrogel Food Packaging. Carbohydr. Polym. 2015, 117, 559–568. [Google Scholar] [CrossRef] [PubMed]
- Awasthi, R.; Manchanda, S.; Das, P.; Velu, V.; Malipeddi, H.; Pabreja, K.; Pinto, T.D.J.A.; Gupta, G.; Dua, K. 9—Poly(Vinylpyrrolidone). In Engineering of Biomaterials for Drug Delivery Systems; Parambath, A., Ed.; Woodhead Publishing Series in Biomaterials; Woodhead Publishing: Sawston, UK, 2018; pp. 255–272. [Google Scholar] [CrossRef]
- Roy, N.; Saha, N. PVP-Based Hydrogels: Synthesis, Properties and Applications. 2012, pp. 227–252. Available online: https://www.researchgate.net/publication/286215035_PVP-based_hydrogels_Synthesis_properties_and_applications (accessed on 1 December 2024).
- Franco, P.; De Marco, I. The Use of Poly(N-Vinyl Pyrrolidone) in the Delivery of Drugs: A Review. Polymers 2020, 12, 1114. [Google Scholar] [CrossRef] [PubMed]
- Li, Y.; Dong, Q.; Chen, J.; Li, L. Effects of Coaxial Electrospun Eugenol Loaded Core-Sheath PVP/Shellac Fibrous Films on Postharvest Quality and Shelf Life of Strawberries. Postharvest Biol. Technol. 2020, 159, 111028. [Google Scholar] [CrossRef]
- Gong, M.; Zhang, L.; Zuo, Y.; Zou, Q.; Wang, Y.; Wang, L.; Li, Y. Investigation on the Interpenetrating Polymer Networks (Ipns) of Polyvinyl Alcohol and Poly(N-Vinyl Pyrrolidone) Hydrogel and Its in Vitro Bioassessment. J. Appl. Polym. Sci. 2012, 125, 2799–2806. [Google Scholar] [CrossRef]
- Poly(vinyl alcohol)-poly(vinyl pyrrolidone) Blends: Preparation and Characterization for a Prospective Medical Application. Available online: https://scholar.googleusercontent.com/scholar?q=cache:_HhKslrzYi4J:scholar.google.com/+Bernal,+A.,+Kuritka,+I.+V.+O.+%26+Saha,+P.+Poly+(+vinyl+alcohol+)+-poly+(+vinyl+pyrrolidone++)+blends%E2%80%AF:+Preparation+and+characterization+for+a+prospective+medical+application+2++Problem+Formulation+3+Problem+Solution.+431%E2%80%93434&hl=en&as_sdt=0,5 (accessed on 6 April 2024).
- Leone, G.; Consumi, M.; Pepi, S.; Pardini, A.; Bonechi, C.; Tamasi, G.; Donati, A.; Rossi, C.; Magnani, A. Poly-Vinyl Alcohol (PVA) Crosslinked by Trisodium Trimetaphosphate (STMP) and Sodium Hexametaphosphate (SHMP): Effect of Molecular Weight, pH and Phosphorylating Agent on Length of Spacing Arms, Crosslinking Density and Water Interaction. J. Mol. Struct. 2020, 1202, 127264. [Google Scholar] [CrossRef]
- Adelnia, H.; Ensandoost, R.; Shebbrin Moonshi, S.; Gavgani, J.N.; Vasafi, E.I.; Ta, H.T. Freeze/Thawed Polyvinyl Alcohol Hydrogels: Present, Past and Future. Eur. Polym. J. 2022, 164, 110974. [Google Scholar] [CrossRef]
- Seera, S.D.K.; Kundu, D.; Banerjee, T. Physical and Chemical Crosslinked Microcrystalline Cellulose-Polyvinyl Alcohol Hydrogel: Freeze–Thaw Mediated Synthesis, Characterization and in Vitro Delivery of 5-Fluorouracil. Cellulose 2020, 27, 6521–6535. [Google Scholar] [CrossRef]
- Gosecka, M.; Gosecki, M.; Jaworska-Krych, D. Hydrophobized Hydrogels: Construction Strategies, Properties, and Biomedical Applications. Adv. Funct. Mater. 2023, 33, 2212302. [Google Scholar] [CrossRef]
- Mushtaq, F.; Raza, Z.A.; Batool, S.R.; Zahid, M.; Onder, O.C.; Rafique, A.; Nazeer, M.A. Preparation, Properties, and Applications of Gelatin-Based Hydrogels (GHs) in the Environmental, Technological, and Biomedical Sectors. Int. J. Biol. Macromol. 2022, 218, 601–633. [Google Scholar] [CrossRef] [PubMed]
- Syed, I.; Garg, S.; Sarkar, P. 5—Entrapment of Essential Oils in Hydrogels for Biomedical Applications. In Polymeric Gels; Pal, K., Banerjee, I., Eds.; Woodhead Publishing Series in Biomaterials; Woodhead Publishing: Sawston, UK, 2018; pp. 125–141. [Google Scholar] [CrossRef]
- Malka, E.; Caspi, A.; Cohen, R.; Margel, S. Fabrication and Characterization of Hydrogen Peroxide and Thymol-Loaded PVA/PVP Hydrogel Coatings as a Novel Anti-Mold Surface for Hay Protection. Polymers 2022, 14, 5518. [Google Scholar] [CrossRef]
- Stan, D.; Tanase, C.; Avram, M.; Apetrei, R.; Mincu, N.-B.; Mateescu, A.L.; Stan, D. Wound Healing Applications of Creams and “Smart” Hydrogels. Exp. Dermatol. 2021, 30, 1218–1232. [Google Scholar] [CrossRef]
- Järbrink, K.; Ni, G.; Sönnergren, H.; Schmidtchen, A.; Pang, C.; Bajpai, R.; Car, J. The Humanistic and Economic Burden of Chronic Wounds: A Protocol for a Systematic Review. Syst. Rev. 2017, 6, 15. [Google Scholar] [CrossRef] [PubMed]
- Ahmed, S.K.; Hussein, S.; Qurbani, K.; Ibrahim, R.H.; Fareeq, A.; Mahmood, K.A.; Mohamed, M.G. Antimicrobial Resistance: Impacts, Challenges, and Future Prospects. J. Med. Surg. Public Health 2024, 2, 100081. [Google Scholar] [CrossRef]
- Li, J.; Mooney, D.J. Designing Hydrogels for Controlled Drug Delivery. Nat. Rev. Mater. 2016, 1, 16071. [Google Scholar] [CrossRef] [PubMed]
- Fu, M.; Liang, Y.; Lv, X.; Li, C.; Yang, Y.Y.; Yuan, P.; Ding, X. Recent Advances in Hydrogel-Based Anti-Infective Coatings. J. Mater. Sci. Technol. 2021, 85, 169–183. [Google Scholar] [CrossRef]
- Ng, V.W.L.; Chan, J.M.W.; Sardon, H.; Ono, R.J.; García, J.M.; Yang, Y.Y.; Hedrick, J.L. Antimicrobial Hydrogels: A New Weapon in the Arsenal against Multidrug-Resistant Infections. Adv. Drug Deliv. Rev. 2014, 78, 46–62. [Google Scholar] [CrossRef]
- Wound Pathophysiology, Infection and Therapeutic Options: Annals of Medicine: Vol 34, No 6. Available online: https://www.tandfonline.com/doi/abs/10.1080/078538902321012360 (accessed on 31 August 2024).
- Murphy, E.C.; Friedman, A.J. Hydrogen Peroxide and Cutaneous Biology: Translational Applications, Benefits, and Risks. J. Am. Acad. Dermatol. 2019, 81, 1379–1386. [Google Scholar] [CrossRef]
- Ding, B.; Chi, S.G.; Kim, S.H.; Kang, S.; Cho, J.H.; Kim, D.S.; Cho, N.H. Role of P53 in Antioxidant Defense of HPV-Positive Cervical Carcinoma Cells Following H2O2 Exposure. J. Cell Sci. 2007, 120, 2284–2294. [Google Scholar] [CrossRef] [PubMed]
- Polaka, S.; Katare, P.; Pawar, B.; Vasdev, N.; Gupta, T.; Rajpoot, K.; Sengupta, P.; Tekade, R.K. Emerging ROS-Modulating Technologies for Augmentation of the Wound Healing Process. ACS Omega 2022, 7, 30657–30672. [Google Scholar] [CrossRef] [PubMed]
- Hoogenkamp, M.A.; Mazurel, D.; Deutekom-Mulder, E.; de Soet, J.J. The Consistent Application of Hydrogen Peroxide Controls Biofilm Growth and Removes Vermamoeba vermiformis from Multi-Kingdom in-Vitro Dental Unit Water Biofilms. Biofilm 2023, 5, 100132. [Google Scholar] [CrossRef]
- Hughes, R.; Andrew, P.W.; Kilvington, S. Enhanced Killing of Acanthamoeba Cysts with a Plant Peroxidase-Hydrogen Peroxide-Halide Antimicrobial System. Appl. Environ. Microbiol. 2003, 69, 2563–2567. [Google Scholar] [CrossRef] [PubMed]
- Cao, S.; Wang, Q.; Zhou, Z.; Lv, F.; Zhai, M.; Zhao, W.; Chen, H.; Yu, G.; Xin, H.; Wang, X. A Smart Band-Aid with Temperature and Reactive Oxygen Species Dual-Responsiveness for Synergistic Mechanical and Pharmacological Therapy of Chronic Wounds. Chem. Eng. J. 2024, 487, 150550. [Google Scholar] [CrossRef]
- He, X.Y.; Sun, A.; Li, T.; Qian, Y.J.; Qian, H.; Ling, Y.F.; Zhang, L.H.; Liu, Q.Y.; Peng, T.; Qian, Z. Mussel-Inspired Antimicrobial Gelatin/Chitosan Tissue Adhesive Rapidly Activated in Situ by H2O2/Ascorbic Acid for Infected Wound Closure. Carbohydr. Polym. 2020, 247, 116692. [Google Scholar] [CrossRef]
- Topaz, M.; Chorin, E.; Schwartz, A.L.; Hochstadt, A.; Shotan, A.; Ashkenazi, I.; Kazatsker, M.; Carmel, N.-N.; Topaz, G.; Oron, Y.; et al. Regional Antibiotic Delivery for Implanted Cardiovascular Electronic Device Infections. J. Am. Coll. Cardiol. 2023, 81, 119–133. [Google Scholar] [CrossRef]
- Dogan-Guner, E.M.; Mohamed, H.; Orbey, N.; Goodyear, N. Stabilization and Controlled Release of Micro-Encapsulated Hydrogen Peroxide for Wound Treatment Applications. J. Appl. Microbiol. 2019, 126, 965–972. [Google Scholar] [CrossRef]
- Zhu, G.; Wang, Q.; Lu, S.; Niu, Y. Hydrogen Peroxide: A Potential Wound Therapeutic Target? Med. Princ. Pract. 2017, 26, 301–308. [Google Scholar] [CrossRef] [PubMed]
- Boonpoempoon, T.; Wonsawat, W.; Kaneta, T. Long-Term Stabilization of Hydrogen Peroxide by Poly(Vinyl Alcohol) on Paper-Based Analytical Devices. Sci. Rep. 2019, 9, 12951. [Google Scholar] [CrossRef] [PubMed]
- Chambers, L.I.; Yufit, D.S.; Fox, M.A.; Musa, O.M.; Steed, J.W. Structure and Hydration of Polyvinylpyrrolidone–Hydrogen Peroxide. Chem. Commun. 2022, 58, 80–83. [Google Scholar] [CrossRef] [PubMed]
- Borjihan, Q.; Meng, S.; Bai, H.; Chen, T.; Hu, X.; Xiao, D.; Shi, L.; Dong, A. Active Iodine Regulated in Cow Dung Biochar-Based Hydrogel Combined with PDT/PTT for MRSA Infected Wound Therapy. Mater. Des. 2023, 231, 112051. [Google Scholar] [CrossRef]
- Brumberg, V.; Astrelina, T.; Malivanova, T.; Samoilov, A. Modern Wound Dressings: Hydrogel Dressings. Biomedicines 2021, 9, 1235. [Google Scholar] [CrossRef]
- Lu, Y.; Hu, M.; Huang, Y.; Liao, J.; Zhao, M.; Zhou, Y.; Xia, G.; Zhan, Q. Preparation of Multifunctional Hydrogels with In Situ Dual Network Structure and Promotion of Wound Healing. Biomacromolecules 2024, 25, 4965–4976. [Google Scholar] [CrossRef] [PubMed]
- Huang, Y.; Fu, Z.; Wang, H.; Liu, Z.; Gao, M.; Luo, Y.; Zhang, M.; Wang, J.; Ni, D. Calcium Peroxide-Based Hydrogels Enable Biphasic Release of Hydrogen Peroxide for Infected Wound Healing. Adv. Sci. 2024, 11, 2404813. [Google Scholar] [CrossRef]
- Song, W.; You, J.; Zhang, Y.; Yang, Q.; Jiao, J.; Zhang, H. Recent Studies on Hydrogels Based on H2O2-Responsive Moieties: Mechanism, Preparation and Application. Gels 2022, 8, 361. [Google Scholar] [CrossRef]
- Serra, R.; Grande, R.; Butrico, L.; Rossi, A.; Settimio, U.F.; Caroleo, B.; Amato, B.; Gallelli, L.; de Franciscis, S. Chronic Wound Infections: The Role of Pseudomonas Aeruginosa and Staphylococcus Aureus. Expert Rev. Anti-Infect. Ther. 2015, 13, 605–613. [Google Scholar] [CrossRef]
- Thi, M.T.T.; Wibowo, D.; Rehm, B.H.A. Pseudomonas Aeruginosa Biofilms. Int. J. Mol. Sci. 2020, 21, 8671. [Google Scholar] [CrossRef]
- Fiore, E.; Van Tyne, D.; Gilmore, M.S. Pathogenicity of Enterococci. Microbiol Spectr 2019, 7, 10–1128. [Google Scholar] [CrossRef] [PubMed]
- Alharbi, N.S.; Khaled, J.M.; Kadaikunnan, S.; Alobaidi, A.S.; Sharafaddin, A.H.; Alyahya, S.A.; Almanaa, T.N.; Alsughayier, M.A.; Shehu, M.R. Prevalence of Escherichia coli Strains Resistance to Antibiotics in Wound Infections and Raw Milk. Saudi J. Biol. Sci. 2019, 26, 1557–1562. [Google Scholar] [CrossRef] [PubMed]
- Heatley, N.G. A Method for the Assay of Penicillin. Biochem. J. 1944, 38, 61–65. [Google Scholar] [CrossRef]
- Hasanbeigi, A.; Shahmir, P.; Amraei, M. Study of Antifungal Resistance of Candida Types Against Some of Common Antifungus Drugs. Int. J. Pharm. Sci. Res. 2015, 6, 241–244. [Google Scholar]
- Balouiri, M.; Sadiki, M.; Ibnsouda, S.K. Methods for in Vitro Evaluating Antimicrobial Activity: A Review. J. Pharm. Anal. 2016, 6, 71–79. [Google Scholar] [CrossRef] [PubMed]
- Yin, D.; Guo, Y.; Li, M.; Wu, W.; Tang, J.; Liu, Y.; Chen, F.; Ni, Y.; Sun, J.; Zhang, H.; et al. Performance of VITEK 2, E-Test, Kirby–Bauer Disk Diffusion, and Modified Kirby–Bauer Disk Diffusion Compared to Reference Broth Microdilution for Testing Tigecycline Susceptibility of Carbapenem-Resistant K. Pneumoniae and A. Baumannii in a Multicenter Study in China. Eur. J. Clin. Microbiol. Infect. Dis. 2021, 40, 1149–1154. [Google Scholar] [CrossRef] [PubMed]
- Gallin, W.J.; Hepperle, B. Burn Healing in Organ Cultures of Embryonic Chicken Skin: A Model System. Burns 1998, 24, 613–620. [Google Scholar] [CrossRef] [PubMed]
- Serinçay, H.; Özkan, S.; Yılmaz, N.; Koçyiğit, S.; Uslu, İ.; Gürcan, S.; Arısoy, M. PVA/PAA-Based Antibacterial Wound Dressing Material with Aloe Vera. Polym. -Plast. Technol. Eng. 2013, 52, 1308–1315. [Google Scholar] [CrossRef]
- Wu, X.; Yang, M.; Kim, J.S.; Wang, R.; Kim, G.; Ha, J.; Kim, H.; Cho, Y.; Nam, K.T.; Yoon, J. Reactivity Differences Enable ROS for Selective Ablation of Bacteria. Angew. Chem. 2022, 134, e202200808. [Google Scholar] [CrossRef]
- Tavares, T.D.; Antunes, J.C.; Padrão, J.; Ribeiro, A.I.; Zille, A.; Amorim, M.T.P.; Ferreira, F.; Felgueiras, H.P. Activity of Specialized Biomolecules against Gram-Positive and Gram-Negative Bacteria. Antibiotics 2020, 9, 314. [Google Scholar] [CrossRef]
- Won, J.; Kang, H.; Baek, S.; Kwon, S. Experimental Study on Evaporation Characteristics of a Hydrogen Peroxide Droplet at Elevated Temperature. IOP Conf. Ser. Earth Environ. Sci. 2017, 67, 012037. [Google Scholar] [CrossRef]
- Leone, G.; Consumi, M.; Aggravi, M.; Donati, A.; Lamponi, S.; Magnani, A. PVA/STMP Based Hydrogels as Potential Substitutes of Human Vitreous. J. Mater. Sci. Mater. Med. 2010, 21, 2491–2500. [Google Scholar] [CrossRef]
- Liu, Z.; Xu, D.; Xia, N.; Zhao, X.; Kong, F.; Wang, S.; Fatehi, P. Preparation and Application of Phosphorylated Xylan as a Flocculant for Cationic Ethyl Violet Dye. Polymers 2018, 10, 317. [Google Scholar] [CrossRef]
- Leone, G.; Consumi, M.; Greco, G.; Bonechi, C.; Lamponi, S.; Rossi, C.; Magnani, A. A PVA/PVP Hydrogel for Human Lens Substitution: Synthesis, Rheological Characterization, and in Vitro Biocompatibility. J. Biomed. Mater. Res. Part B Appl. Biomater. 2011, 97B, 278–288. [Google Scholar] [CrossRef]
- Malka, E.; Dombrovsky, A.; Margel, S. Preparation and Characterization of a Novel PVA/PVP Hydrogel Containing Entrapped Hydrogen Peroxide for Agricultural Applications. ACS Agric. Sci. Technol. 2022, 2, 430–436. [Google Scholar] [CrossRef]
- Shi, Y.; Xiong, D.; Liu, Y.; Wang, N.; Zhao, X. Swelling, Mechanical and Friction Properties of PVA/PVP Hydrogels after Swelling in Osmotic Pressure Solution. Mater. Sci. Eng. C 2016, 65, 172–180. [Google Scholar] [CrossRef] [PubMed]
- Nkhwa, S.; Lauriaga, K.F.; Kemal, E.; Deb, S. Poly(Vinyl Alcohol): Physical Approaches to Designing Biomaterials for Biomedical Applications. Conf. Pap. Sci. 2014, 2014, 403472. [Google Scholar] [CrossRef]
- Yi, Y.; Chiao, M.; Mahmoud, K.A.; Wu, L.; Wang, B. Preparation and Characterization of PVA/PVP Conductive Hydrogels Formed by Freeze–Thaw Processes as a Promising Material for Sensor Applications. J. Mater. Sci. 2022, 57, 8029–8038. [Google Scholar] [CrossRef]
- Holloway, J.L.; Lowman, A.M.; Palmese, G.R. The Role of Crystallization and Phase Separation in the Formation of Physically Cross-Linked PVA Hydrogels. Soft Matter 2013, 9, 826–833. [Google Scholar] [CrossRef]
- Bendaoudi, A.A.; Boudouaia, N.; Jellali, S.; Benhafsa, F.M.; Bengharez, Z.; Papamichael, I.; Jeguirim, M. Facile Synthesis of Double-Cross-Linked Alginate-Based Hydrogel: Characterization and Use in a Context of Circular Economy for Cationic Dye Removal. Waste Manag. Res. 2024, 42, 495–507. [Google Scholar] [CrossRef] [PubMed]
- Meng, X.; Sun, Y.; Wang, L.; Li, Y.; Ouyang, R.; Yuan, P.; Miao, Y. Slow Release of Oxygen from Carbamide Peroxide for Promoting the Proliferation of Human Brain Microvascular Endothelial Cells under Hypoxia. Ann. Transl. Med. 2021, 9, 157. [Google Scholar] [CrossRef] [PubMed]

| Sample Name | PVA (g) | PVP (g) | 30% HP (ml) | DDW (g) |
|---|---|---|---|---|
| PVA/PVP | 3 | 1.2 | - | 15.8 |
| PVA/PVP/HP-1.5 | 3 | 1.2 | 1 | 14.8 |
| PVA/PVP/HP-3 | 3 | 1.2 | 2 | 13.8 |
| PVA/PVP/HP-5 | 3 | 1.2 | 3.3 | 12.5 |
| Sample Name | PVA (g) | PVP (g) | STMP (g) | 30% HP (mL) | DDW (g) |
|---|---|---|---|---|---|
| PVA/PVP-10% STMP | 3 | 1.2 | 0.3 | - | 15.5 |
| PVA/PVP/HP-1.5, 10% STMP | 3 | 1.2 | 0.3 | 1 | 14.5 |
| PVA/PVP/HP-3, 10% STMP | 3 | 1.2 | 0.3 | 2 | 13.5 |
| PVA/PVP/HP-3, 20% STMP | 3 | 1.2 | 0.6 | 2 | 13.2 |
| PVA/PVP/HP-5, 10% STMP | 3 | 1.2 | 0.3 | 3.3 | 12. 2 |
Disclaimer/Publisher’s Note: The statements, opinions and data contained in all publications are solely those of the individual author(s) and contributor(s) and not of MDPI and/or the editor(s). MDPI and/or the editor(s) disclaim responsibility for any injury to people or property resulting from any ideas, methods, instructions or products referred to in the content. |
© 2025 by the authors. Licensee MDPI, Basel, Switzerland. This article is an open access article distributed under the terms and conditions of the Creative Commons Attribution (CC BY) license (https://creativecommons.org/licenses/by/4.0/).
Share and Cite
Mounayer, N.; Shoshani, S.; Afrimzon, E.; Iline-Vul, T.; Topaz, M.; Banin, E.; Margel, S. Encapsulation of Hydrogen Peroxide in PVA/PVP Hydrogels for Medical Applications. Gels 2025, 11, 31. https://doi.org/10.3390/gels11010031
Mounayer N, Shoshani S, Afrimzon E, Iline-Vul T, Topaz M, Banin E, Margel S. Encapsulation of Hydrogen Peroxide in PVA/PVP Hydrogels for Medical Applications. Gels. 2025; 11(1):31. https://doi.org/10.3390/gels11010031
Chicago/Turabian StyleMounayer, Natalie, Sivan Shoshani, Elena Afrimzon, Taly Iline-Vul, Moris Topaz, Ehud Banin, and Shlomo Margel. 2025. "Encapsulation of Hydrogen Peroxide in PVA/PVP Hydrogels for Medical Applications" Gels 11, no. 1: 31. https://doi.org/10.3390/gels11010031
APA StyleMounayer, N., Shoshani, S., Afrimzon, E., Iline-Vul, T., Topaz, M., Banin, E., & Margel, S. (2025). Encapsulation of Hydrogen Peroxide in PVA/PVP Hydrogels for Medical Applications. Gels, 11(1), 31. https://doi.org/10.3390/gels11010031

